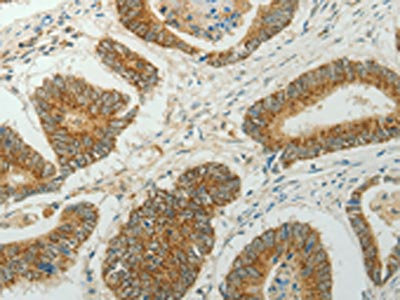

CCND1 Antibody
-
中文名稱:CCND1兔多克隆抗體
-
貨號:CSB-PA516472
-
規格:¥1100
-
圖片:
-
The image on the left is immunohistochemistry of paraffin-embedded Human colon cancer tissue using CSB-PA516472(CCND1 Antibody) at dilution 1/50, on the right is treated with fusion protein. (Original magnification: ×200)
-
The image on the left is immunohistochemistry of paraffin-embedded Human lung cancer tissue using CSB-PA516472(CCND1 Antibody) at dilution 1/50, on the right is treated with fusion protein. (Original magnification: ×200)
-
-
其他:
產品詳情
-
Uniprot No.:
-
基因名:
-
別名:AI327039 antibody; B cell CLL/lymphoma 1 antibody; B cell leukemia 1 antibody; B cell lymphoma 1 protein antibody; B-cell lymphoma 1 protein antibody; BCL 1 antibody; BCL-1 antibody; BCL-1 oncogene antibody; BCL1 antibody; BCL1 oncogene antibody; ccnd1 antibody; CCND1/FSTL3 fusion gene antibody; CCND1/FSTL3 fusion gene; included antibody; CCND1/IGHG1 fusion gene antibody; CCND1/IGHG1 fusion gene; included antibody; CCND1/IGLC1 fusion gene antibody; CCND1/IGLC1 fusion gene; included antibody; CCND1/PTH fusion gene antibody; CCND1/PTH fusion gene; included antibody; CCND1_HUMAN antibody; cD1 antibody; Cyl 1 antibody; D11S287E antibody; G1/S specific cyclin D1 antibody; G1/S-specific cyclin-D1 antibody; Parathyroid adenomatosis 1 antibody; PRAD1 antibody; PRAD1 oncogene antibody; U21B31 antibody
-
宿主:Rabbit
-
反應種屬:Human
-
免疫原:Fusion protein of Human CCND1
-
免疫原種屬:Homo sapiens (Human)
-
標記方式:Non-conjugated
-
抗體亞型:IgG
-
純化方式:Antigen affinity purification
-
濃度:It differs from different batches. Please contact us to confirm it.
-
保存緩沖液:-20°C, pH7.4 PBS, 0.05% NaN3, 40% Glycerol
-
產品提供形式:Liquid
-
應用范圍:ELISA,IHC
-
推薦稀釋比:
Application Recommended Dilution ELISA 1:1000-1:2000 IHC 1:50-1:200 -
Protocols:
-
儲存條件:Upon receipt, store at -20°C or -80°C. Avoid repeated freeze.
-
貨期:Basically, we can dispatch the products out in 1-3 working days after receiving your orders. Delivery time maybe differs from different purchasing way or location, please kindly consult your local distributors for specific delivery time.
-
用途:For Research Use Only. Not for use in diagnostic or therapeutic procedures.
相關產品
靶點詳情
-
功能:Regulatory component of the cyclin D1-CDK4 (DC) complex that phosphorylates and inhibits members of the retinoblastoma (RB) protein family including RB1 and regulates the cell-cycle during G(1)/S transition. Phosphorylation of RB1 allows dissociation of the transcription factor E2F from the RB/E2F complex and the subsequent transcription of E2F target genes which are responsible for the progression through the G(1) phase. Hypophosphorylates RB1 in early G(1) phase. Cyclin D-CDK4 complexes are major integrators of various mitogenenic and antimitogenic signals. Also substrate for SMAD3, phosphorylating SMAD3 in a cell-cycle-dependent manner and repressing its transcriptional activity. Component of the ternary complex, cyclin D1/CDK4/CDKN1B, required for nuclear translocation and activity of the cyclin D-CDK4 complex. Exhibits transcriptional corepressor activity with INSM1 on the NEUROD1 and INS promoters in a cell cycle-independent manner.
-
基因功能參考文獻:
- LINC01296 is an oncogenic lncRNA in osteosarcoma. The proliferation, invasion and migration of osteosarcoma cells could be effectively retarded by inhibition of LINC01296. The cancerpromoting effect of LINC01296 on osteosarcoma was determined by cyclin D1. PMID: 30226542
- autophagic degradation machinery and cyclin D1 linked to hepatocellular carcinoma tumorigenesis PMID: 29328502
- FOXD2-AS1 could promote the growth of chondrocytes by targeting miR-206/CCND1 axis. PMID: 30119190
- CCND1 , C-MYC , and FGFR1 amplifications were observed in 34.28%, 28.57%, and 17.14% of the 35 samples (invasive ductal breast carcinoma). PMID: 30119151
- High CCND1 expression is associated with lung adenocarcinoma. PMID: 30066899
- Down-regulation of Apaf-1 protein and the overexpression of Cyclin D1 and AQP-5 proteins possibly contribute to an aggressive serous ovarian carcinoma with a high risk of recurrence and poor response to the first-line chemotherapy. PMID: 30072015
- Results provide evidence that Cyclin D1 is a mediator for WDR5-induced proliferation and cell cycle change in gastric neoplasm. PMID: 29125890
- CNV analysis disclosed that plasma CCND1/CDKN2A ratio is correlated with EBV DNA load in NPC patients' plasma and could serve as a screening test to select potential CDK4/6 inhibitor treatment candidates. Based on our NPC PDX model and RNA sequencing, Palbociclib, a cyclin-dependent kinase inhibitor, proved to have anti-tumor effects by inducing G1 arrest. PMID: 30236142
- Cyclin D1b markedly amplified integrin alphavbeta3 expression, which was further up-regulated under lipopolysaccharide stimulation. PMID: 30074214
- This meta-analysis suggested that CCND1 rs9344 polymorphism might be associated with the risk of HCC among Caucasians. PMID: 29970717
- Results show that CCND1 expression is regulated by LET7A which directly targets its 3'UTR in A549 lung cancer cells. PMID: 30201337
- Authors found that the phenotypic alterations by miR-365 were partially due to downregulation of CCND1 and BCL2 oncogenes. PMID: 29858490
- USP22 and CCND1 levels correlate in patient lung and colorectal cancer samples and our preclinical studies indicate that targeting USP22 in combination with CDK inhibitors may offer an approach for treating cancer patients whose tumors exhibit elevated CCND1. PMID: 30224477
- miR449a5p may control squamous cell carcinoma proliferation through the negative regulation of cyclin D1 expression. PMID: 29845226
- Findings demonstrated that Cyclin D1 is overexpressed in hepatocellular carcinoma cells (HCC) and that its silencing can suppress cell proliferation and promote cell apoptosis of HCC. PMID: 28885717
- uc.338 could promote proliferation and cell cycle G1/S transition, and might target p21 downregulation and cyclin D1 upregulation. PMID: 29901203
- overexpressed PKM2 led to increased CCND1 and decreased CDKN1A expression, whereas underexpressed PKM2 led to decreased CCND1 and increased CDKN1A expression in ovarian cancer cells. PMID: 29752805
- CCND1 G870A polymorphism may increase the risk of lung cancer in smokers from North India, and it may be associated with the overall survival of small-cell lung cancer patients PMID: 30086699
- these results define a tumor-supportive role for CDCA3. PMID: 29627567
- High CCND1 expression is associated with breast cancer. PMID: 29047106
- The novel EGR1-CCND1 axis contributes to the G1 phase arrest and cell proliferation in glioma PMID: 29246166
- the focal adhesion component paxillin is a cytoplasmic substrate of Ccnd1.Cdk4. PMID: 27181366
- in oral tumor cells, overexpression of cyclin D1 occurs through the activation of STAT3 and the deregulation of degradation pathway of cyclin D1 which may favors maintaining its accumulated level in cells. It also demonstrated that cyclin D1 expression can be controlled by targeting the STAT3 with its siRNA. PMID: 29516928
- more than 50 cyclin D1-positive cells per high-power field were detected within the proliferation centres PMID: 29254788
- Downregulation of miR-138 increases the gene and protein expression of its potential target CCND1 in OLP mucosa which might have a pivotal role in the disease pathogenesis. PMID: 28275859
- A possible contribution of cyclin D1 and hnRNP-K expression in the initiation and progression of urinary bladder carcinoma. PMID: 29480994
- Un-methyaltion at -56 and -54 bp CpG in the CCND1 promoter serves as a predictor for invasive progression in arsenic-induced Bowen's disease patients. PMID: 29103775
- PSAT1, which is overexpressed in ER-negative breast cancers, is activated by ATF4 and promotes cell cycle progression via regulation of the GSK3beta/beta-catenin/cyclin D1 pathway. PMID: 29216929
- Positivity of p53 and cyclin D1 was not found to be predictive of survival in patients with esophageal SCC which might be due to the small sample size of the present survey. PMID: 27975182
- Studied effects of Taxillus yadoriki and Neolitsea sericea extracts on cell proliferation of cancer cells through cyclin D1 proteasomal degradation. PMID: 29925351
- Findings indicate the substrate specificity of the F-box protein FBXO31 and the mechanism of FBXO31-regulated cyclin D1 protein turnover. PMID: 29279382
- The authors report a previously unknown long noncoding RNA which, together with CNBP, is involved in the fine-tuned regulation of CCND1 mRNA stability, without which CCND1 exhibits, at most, partial expression. PMID: 29199958
- According to immunohistochemistry and immunoblot analysis, the expression levels of cyclin D1, cyclin E, pRb, and Ki67 in psoriasis lesions decreased after treatment and were similar with those in the normal group PMID: 29115643
- Further study revealed AP000439.3 can regulate expression of CCND1 through enhancing estrogen receptor induction of CCND1. This finding revealed lncRNAs may serve as important effectors of ER in regulation of gene expression and cell phenotype in breast cancer PMID: 29048636
- miR-720 acted as a tumour suppressor in pancreatic cancer by directly targeting CCND1. PMID: 28990111
- Results identified NKX2-1-binding motifs in the cyclin D1 promoter and indicate that NKX2-1 directly and positively regulates transcription of cyclin D1 in lung adenocarcinoma. PMID: 28634225
- Results suggest that dysregulation and activation of the cell cycle proteins CDK4/CDK6-CCND1-phospho-RB1 axis is associated with higher proliferative index in neuroendocrine tumors (NETs). PMID: 28991877
- Results indicated that miR-193a-3p suppressed gastric growth and motility, at least partly, by directly targeting cyclin D1 (CCND1) and ETS proto-oncogene 1 (ETS1) expression. PMID: 29848678
- Greater frequency of cyclin D1 expression was revealed in normal endometrial tissues in comparison with carcinomas. The distribution pattern of cyclin D1 immunoexpression suggests poor prognoses in endometrial carcinoma patients. PMID: 28965628
- High Expression of CCND1 is associated with liver cancer. PMID: 28415588
- Impact of 9p deletion and p16, Cyclin D1, and Myc hyperexpression on the outcome of anaplastic oligodendrogliomas. PMID: 29489901
- These findings indicate that miRNA494 and its target cyclin D1 may be a crucial axis for Nerve growth factor in regulating the proliferation of human corneal epithelial cell. PMID: 28765880
- INSR rs1051690 SNP is associated with increased risk of gastric cancer, while polymorphisms in IL12B, CCND1 and IL10 genes are not linked with the presence of gastric cancer PMID: 28596683
- Authors showed that CCND1 is a direct target of miR-93, and the dysregulation of the miR-93/CCND1 signaling pathway is responsible for the development of ventricular remodeling. PMID: 28817550
- PD-L1 protein abundance is regulated by cyclin D-CDK4 and the cullin 3-SPOP E3 ligase via proteasome-mediated degradation PMID: 29160310
- We conclude that EMSY and CCND1 work in collaboration and contribute to the pathogenesis of lung cancer. PMID: 28824300
- Transfection of cells with ClC-3 siRNA decreased the expression of cyclin D1, cyclin dependent kinase 4 and 6, and increased the expression of cyclin dependent kinase inhibitors (CDKIs), p21 and p27. Pretreatments of cells with p21 and p27 siRNAs depleted the inhibitory effects of ClC-3 siRNA on the expression of CDK4 and CDK6, but not on that of cyclin D1 PMID: 27451945
- HPV infection was significantly associated with amplification of both EGFR (76.5%) and cyclin D1 (73.0%). PMID: 28741068
- our data demonstrated for the first time that inhibition of RAD51 suppressed the cervical cancer cell proliferation and the growth of cervical cancer xenografts by attenuating cell cycle transition, which could be a functional link between RAD51 and cyclin D1 and p21 PMID: 28627709
- REVIEW: addresses the implication of SOX11 overexpression and frequent genetic lesions, cooperating with cyclin D1 underlying the pathogenesis of mantle cell lymphoma PMID: 28466437
顯示更多
收起更多
-
相關疾病:Multiple myeloma (MM)
-
亞細胞定位:Nucleus. Cytoplasm. Nucleus membrane.
-
蛋白家族:Cyclin family, Cyclin D subfamily
-
數據庫鏈接:
Most popular with customers
-
YWHAB Recombinant Monoclonal Antibody
Applications: ELISA, WB, IHC, IF, FC
Species Reactivity: Human, Mouse, Rat
-
Phospho-YAP1 (S127) Recombinant Monoclonal Antibody
Applications: ELISA, WB, IHC
Species Reactivity: Human
-
-
-
-
-
-